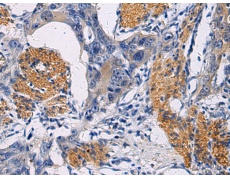
一抗

|
Background: |
This gene encodes a member of the family of secreted protein kinases. The encoded protein binds calcium and phosphorylates proteins involved in bone mineralization. Mutations in this gene are associated with the autosomal recessive disorder Raine syndrome. |
|
Applications: |
ELISA, IHC |
|
Name of antibody: |
FAM20C |
|
Immunogen: |
Synthetic peptide of human FAM20C |
|
Full name: |
FAM20C, golgi associated secretory pathway kinase |
|
Synonyms: |
RNS; DMP4; G-CK; DMP-4; GEF-CK |
|
SwissProt: |
Q8IXL6 |
|
ELISA Recommended dilution: |
2000-5000 |
|
IHC positive control: |
Human esophagus cancer |
|
IHC Recommend dilution: |
50-200 |

 購物車
購物車 幫助
幫助
 021-54845833/15800441009
021-54845833/15800441009